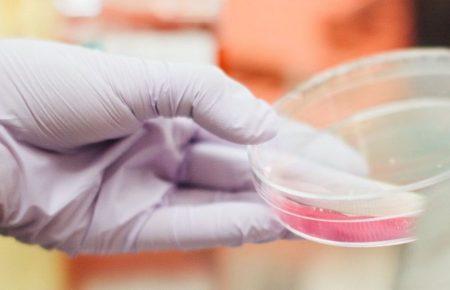
У школі на Одещині на гепатит «А» захворіли четверо дітей — МОЗ

Здоров'я
Обрати рубрику


Росіян та іноземців, евакуйованих із Китаю, у супроводі Росгвардії відвезуть на карантин до Сибіру

В Україні найбільш поширеними є рак молочної залози та легень — заступник міністра

Коронавірус: що відомо про смертельні випадки

ВООЗ прогнозує збільшення кількості ракових захворювань у світі на 60% до 2040 року

Щороку в Україні 140 тисяч людей чують діагноз «рак» — Балан

На Волині 8 тисяч людей захворіли на грип та ГРВІ із початку року

Як приготувати справжню піцу та які бувають різновиди?

У китайській провінції Хубей перебувають 77 українців — посольство

Китай звинувачує США у «розповсюджені паніки» через коронавірус

Мікросвіт навколо нас: біологиня розповіла про мікроби, прийом антибіотиків та плісняву

Україна перенесла діяльність штабу з протидії коронавірусу на рівень Кабміну

Як уникнути ризиків захворювання на грип і коронавірус: домедичні секрети

В Іспанії підтвердили перший випадок нового коронавірусу

Кількість загиблих від коронавірусу зросла до 259, захворіли понад 11 тисяч

За два-три тижні в Україну прибудуть тест-системи для виявлення китайського коронавірусу — Ігор Кузін

До «Борисполя» прибув літак із евакуйованими з Китаю українцями

Перший випадок зараження новим коронавірусом виявили в Індії

Україна за потреби надсилатиме до лабораторії в Лондоні матеріали для тестування на коронавірус